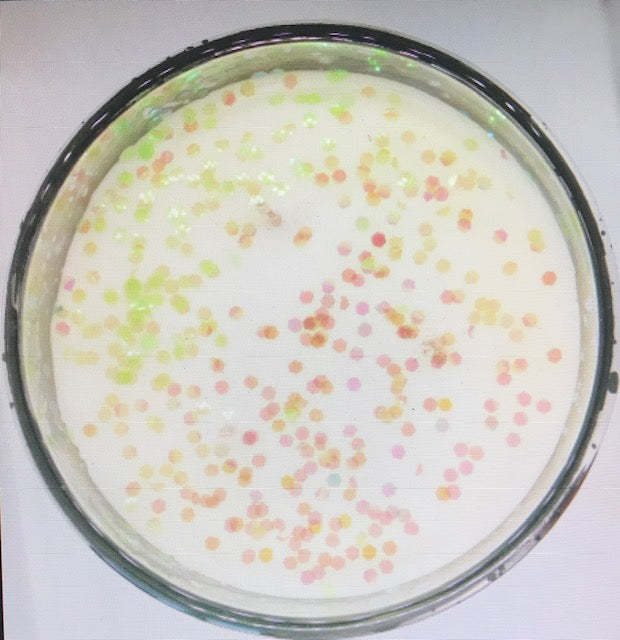
Rickling Grand Candle - Earl Grey & Cucumber

Rickling Candle Company
Rickling Grand Candle - Earl Grey & Cucumber
Rickling Grand Candle - Earl Grey & Cucumber
Couldn't load pickup availability
The Rickling Grand is an impressive chrome candle hand poured in the beautiful village of Rickling Green. Earl Grey & Cucumber is a fresh citrus aromatic fragrance with top notes of bergamot, lemon and earl grey tea leading to a watery floral heart of jasmine, angelica and soft florals with a base of musk, amber, cedar and soft woods.
All of our candles are made with our signature glitter and are individually boxed with a wooden lid. Please contact us if you would like a glitter free item.
Burn time over 50 hours.
Shipping
Shipping
All candles and wax melts are hand poured. We try and keep as much in stock as possible, but we may need to pour your order. Please allow up to 4 days before your order is posted. We will do our best to send out your order as soon as possible.
In order to keep shipping costs to a minimum for our customers, all packages will be sent via Royal Mail 2nd class service. If you require your parcel urgently, please contact us and we can discuss postal options.
In addition to a postal service, we offer our local customers free local delivery within a 7 mile radius of Rickling Green. If you are unsure of the distance, then just email us and we will see if we can deliver to you. Following payment of your order we will contact you via email to arrange a delivery time.
Details of our return policy can be found under the Refund section
Care Instructions
Care Instructions
Caring for your new candle
- Remove all packaging.
- Trim the wick before FIRST use and before each subsequent use. The wick should be no higher than 1/4 “
- Upon the FIRST burn , for optimum use and to prevent tunnelling during the life of the candle, burn the candle until the wax has melted and pooled to the edge of the candle. Once a full melt pool is achieved this will allow the full fragrance to be experienced.
- Keep the wax pool clear of debris and matches to avoid flaring.
- Never leave a burning candle unattended .
- Burn candle in a well ventilated room.
- Do not burn to the bottom of the candle. To prevent overheating discontinue use when 1” of wax remains.
- Always snuff out the candle , do not blow out.
- Leave at least 4” between burning candles.
- Do not burn candles on or near anything that can catch fire.
- Place candle on a heat resistant surface.
- Do not move a burning candle.
- Do not place candles in a draught.
- Do not burn candles for more than 4 hours at a time.
- Extinguish the candle if the flame becomes too high, or the container becomes too hot. Let the candle cool and trim the wick before relighting.
- KEEP AWAY FROM CHILDREN AND PETS
Thank you for making the Rickling Candle Company glow.
How to enjoy your wax melts safely
- Remove all packaging and place 2 sections of your wax melt in the well of your wax melt burner.
- Use with an unscented tea light or electric wax burner.
- Only use a small 4 hour tea light. DO NOT USE AN 8 HOUR TEA LIGHT.
- Only burn the wax melt on a level, fire resistant surface.
- Do not burn for more than 4 hours at a time.
- Do not move whilst lit.
- Do not put fingers, hands or other objects into the unit whilst lit.
- Use in a well ventilated room.
- Do not leave unattended or burning out of sight.
- Do not expose to draughts.
- Do not burn on or near anything that can catch fire.
- Do not overfill the bowl. You can top up once the wax has melted.
- The burner may become hot, do not touch whilst in use as heated wax can burn
- Allow to cool and solidify before moving the unit.
- Keep away from children and pets whilst in use
- STORE WAX MELTS SAFELY AWAY FROM CHILDREN.
- DO NOT EAT!!
Unlike a candle, the wax in a wax melt doesn’t disappear as you use it. Instead, eventually, the wax will lose its scent. When this happens, you will want to remove the wax from the burner to change it over to a fresh new wax melt.
To remove the hardened wax, gently heat with a tea light ,then just pop the slightly soft wax in the bin, do not dispose of any wax down drains.
HAPPY WAX MELTING